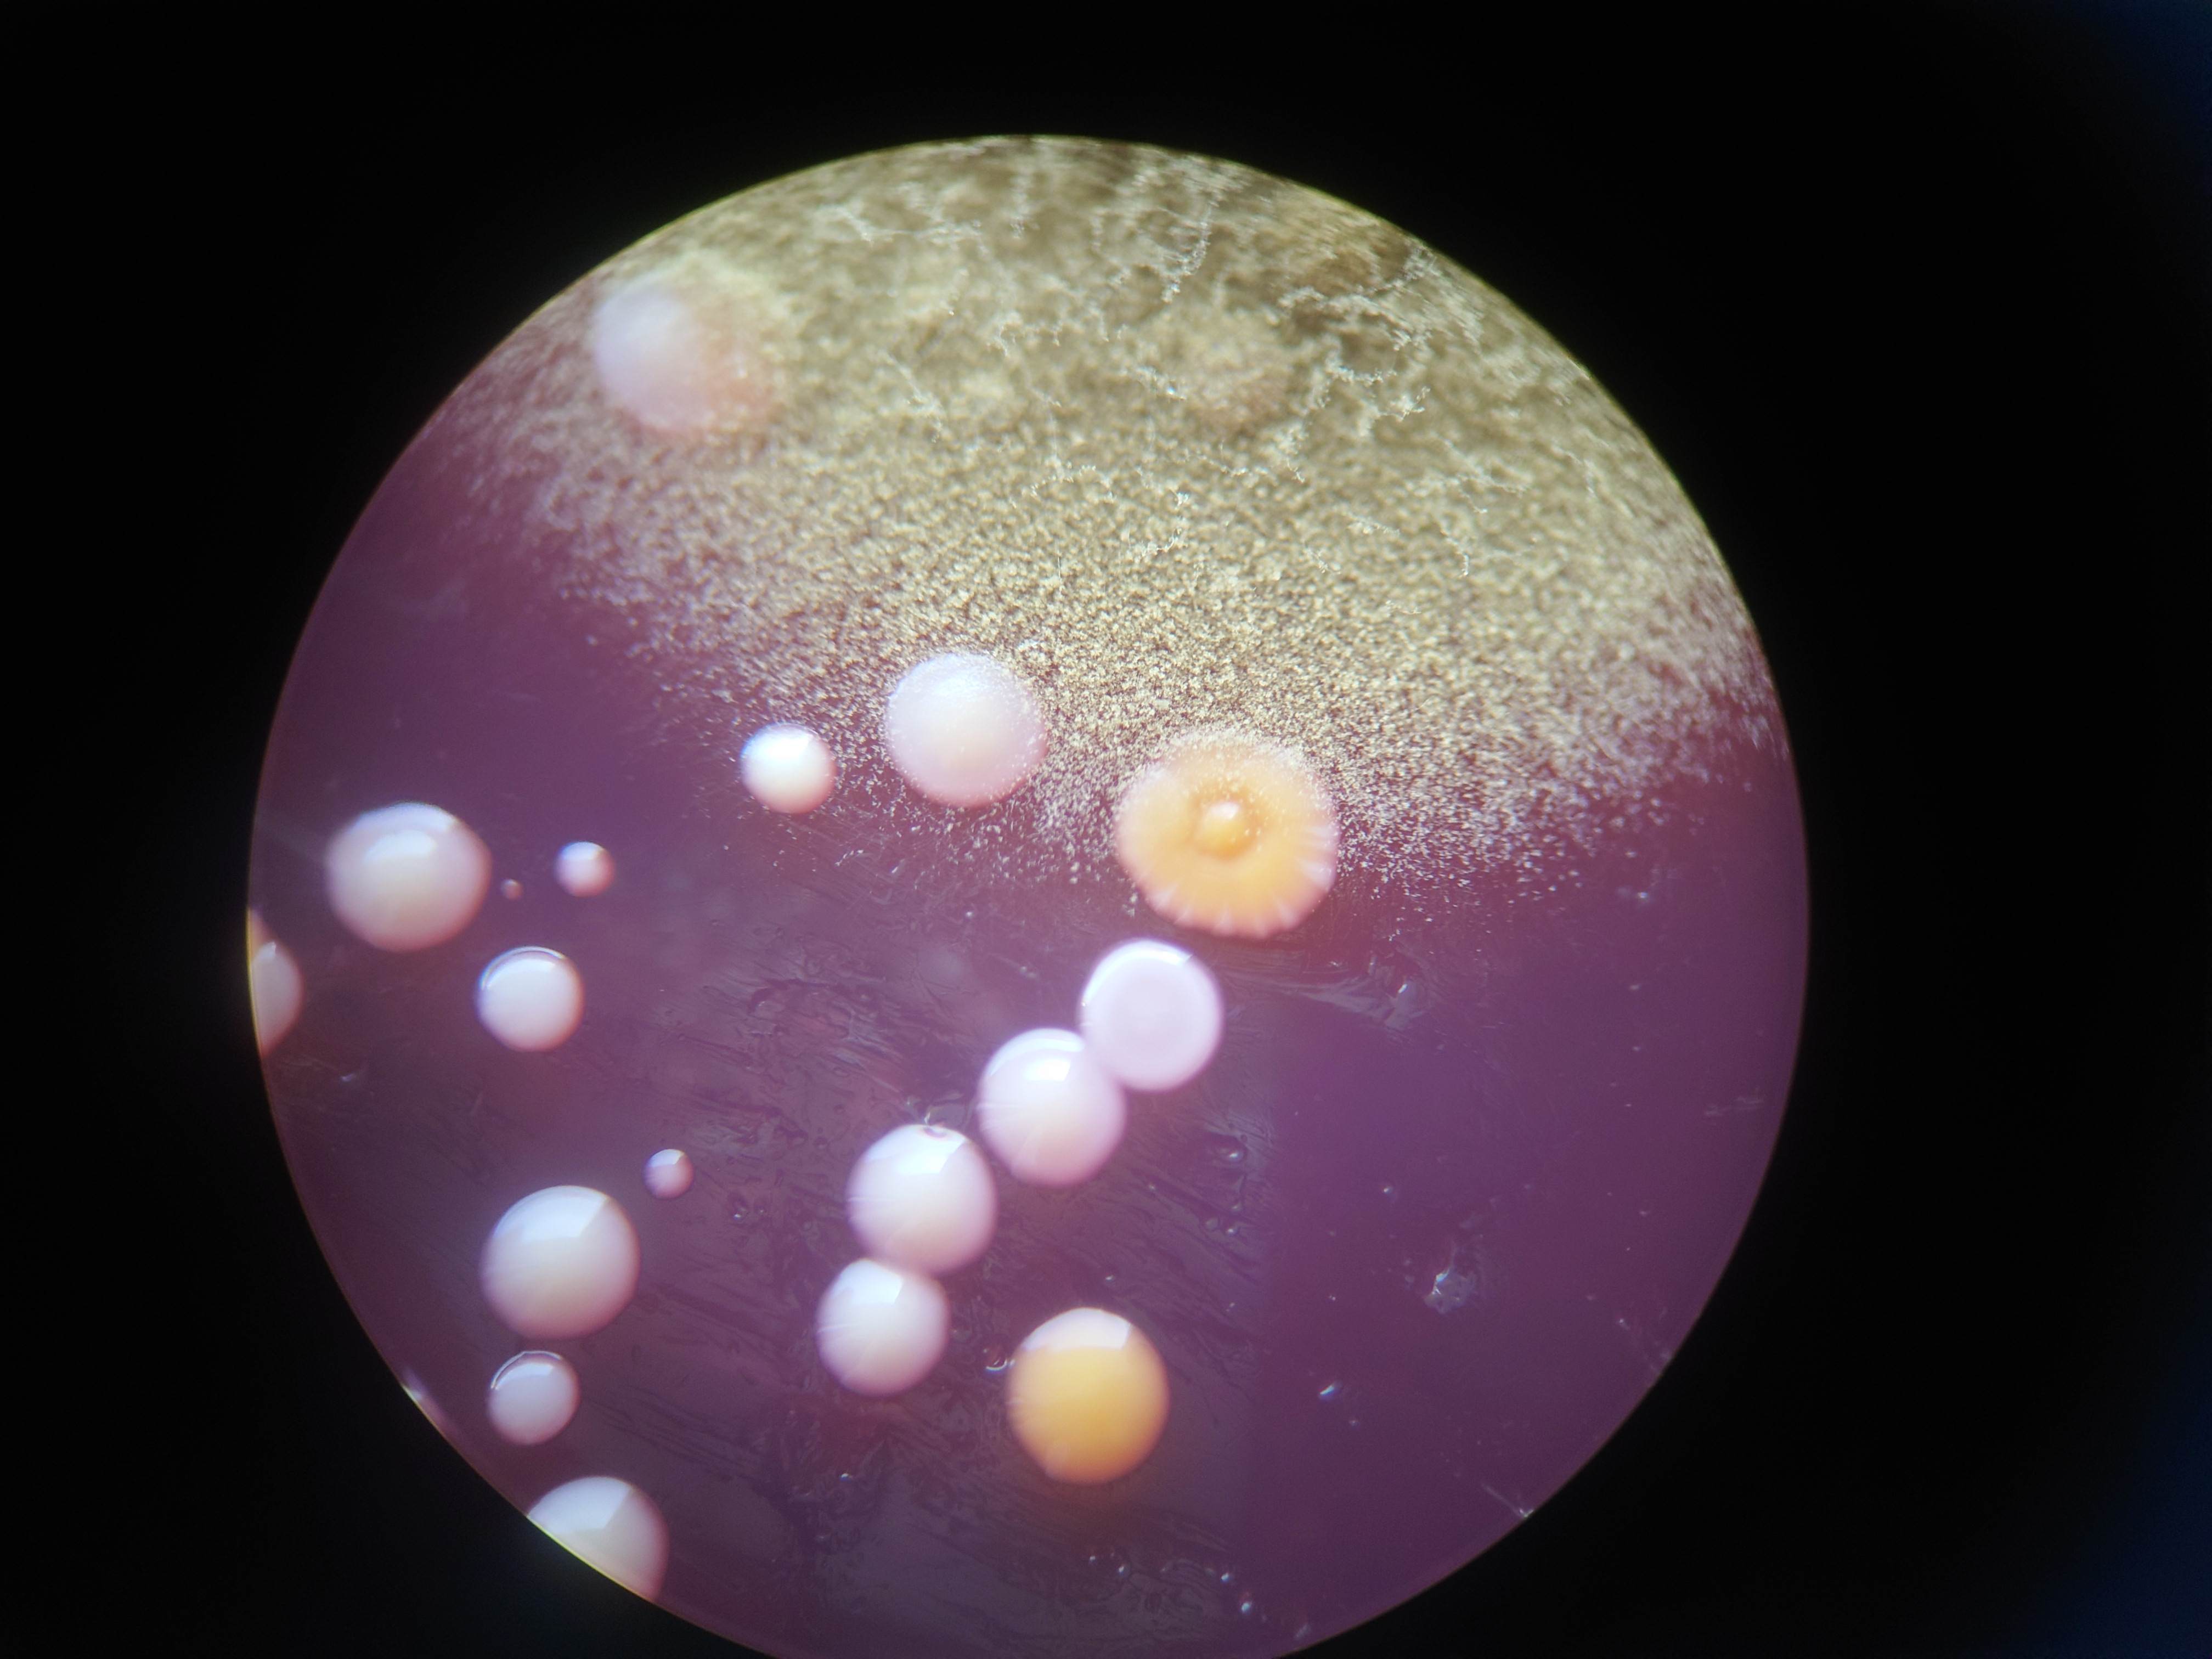
20230724_152646.JPG

こんにちは
桜も開花して暖かくなってきました。さらに新学期も始まり忙しさも感じるようになってきました。
忙しくて食事後の食器を洗うのをさぼってしまうこともあるかと思います。
学生さんより「すぐに食器を洗えないときつけ置きしてして後で洗う場合どれくらいならつけ置きしてもいいですか?」という相談をいただきました。
「1時間以内に洗いましょう」
なぜなら、食後の食器にはたくさんの菌が付着しています。それが時間とともに食べ残しの成分を栄養にして、2個が4個、4個が8個、8個が16個、16個が32個、32個が64個と指数関数的に増えていきますので100倍、1000倍はあっという間です。さらに次の日までおいておくと10万倍以上に増える可能性が出てきてしまいます。
実体顕微鏡でみた雑菌のコロニー
つけ置きのコツは
1.少量の洗剤液をつけ置き水に入れておく。
ただの水よりも、少量の食器用洗剤を混ぜた水につける方が洗剤の界面活性剤作用によって菌が減り増殖しにくくなります。クエン酸をかけておく、重曹をかけておくも酸アルカリによる増殖速度制御になるので良いと思います。ただし、食器を痛める可能性がありますので注意してください。
2.食べ物カスは洗い流しておく。
食べ物のカスは菌のエサになるため。エサを減らしておくと増殖しにくくなります。
もう一つお弁当箱のつけ置きの注意点としてはお弁当箱の蓋のパッキンなどは一度増えてしまうと洗っても10分の1程度しか減らせないのでまずは細菌やカビを増やさなことを心がけましょう。
パッキンは生えたクロカビ
今日も最後までお読みいただきありがとうございました。